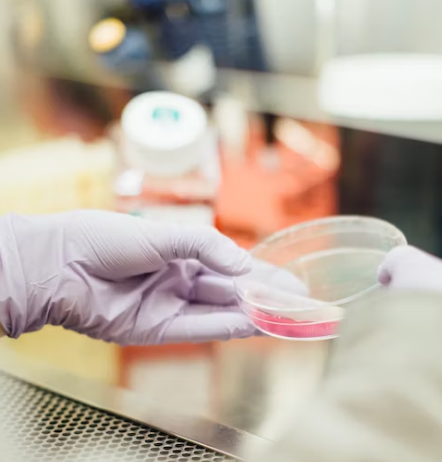

오늘은 배도라지즙의 효능에 대하여 알아보도록 하겠습니다.
배도라지즙 효능
1. 변비 예방
배도라지즙은 변비 예방에 효과가 있습니다. 배도라지즙은 식이섬유가 풍부하고 위에 수분이 많이 함유되어 있어 장 활성화와 변비 예방에 도움이 됩니다. 또한 비타민과 섬유질이 풍부하여 소화를 돕고 배도라지는 따뜻한 특성을 가지고 있어 설사하는 사람에게도 도움이 됩니다.


2. 기관지 질환
배도라지즙은 기관지 질환에 매우 도움이 됩니다. 배도라지는 기관지 질환에 도움이 되는 식품입니다. 이 두 가지가 결합되어 기관지 질환에 더 좋은 영향을 줄 수 있습니다. 위의 루테올린 성분은 폐 염증을 예방하고 기관지 점막 수축을 막아 기침 등 기관지염을 예방할 수 있습니다. 배도라지에는 사포닌도 포함되어 있습니다. 이 성분은 호흡기 질환을 예방하고 기관지 점액 분비를 촉진해 기관지 점막을 강화합니다. 따라서 이 성분들을 조합함으로써 좋은 기관지 질환에 좋은 영향을 줄 수 있습니다.


3. 항암효과
배도라지즙은 항암작용에 효과가 있습니다. 배는 수분 함량이 높아 체내 발암물질 탈출에 도움을 줍니다.
염증을 줄이고 암세포의 발생과 증식을 막아 암세포가 사라지도록 도와주기 때문에 폐암 예방에도 도움이 됩니다.

4. 혈당조절
배도라지즙은 혈당 조절을 돕는 효과가 있습니다. 배도라지즙에는 인슐린 분비를 촉진하는 인슐린 촉진 인자가 포함되어 있어 혈당 조절에 매우 도움이 됩니다.


5. 면역력 강화
배도라지즙 면역력을 강화하는 데 도움이 됩니다. 배의 성분은 면역력 강화에 좋은 아미노산과 유기산이 다량 함유되어 있고 항산화제인 폴리페놀이 풍부하여 면역력 강화에 큰 도움을 줍니다. 배도라지즙에 함유된 비타민C는 피로해소와 면역력 강화에 도움이 됩니다.


6. 숙취해소
배도라지즙은 숙취 해소에 큰 도움이 됩니다. 우리가 흔히 알고 있는 배는 수분이 많고 아스파라긴산이 많이 함유되어 숙취 해소에 도움을 줍니다. 아스파라긴산은 알코올과 에탄이 체내에서 분해되는 것을 도와 숙취 해소에 도움이 됩니다.


7. 간 건강
배도라지즙은 간 건강을 돕는 효과가 있습니다. 배도라지즙에는 간을 돕는 비타민과 식물성 단백질, 아미노산이 풍부하게 포함되어 있습니다. 따라서 배도라지즙은 마실 때 간 건강과 간 기능 향상에 도움이 됩니다.


부작용
1. 혈관에 관계된 약을 먹을 때 주의 필요 합니다.
배도라지 뿌리에 있는 사포닌이라는 성분은 적혈구를 파괴하거나 혈액을 변색시킬 수 있습니다. 따라서 심장질환이나 뇌혈관질환 등 혈관 관련 질환을 앓고 있거나 관련 약물을 복용하고 있다면 주치의와 상담하는 것이 좋습니다.
2. 소화기관 부작용


배도라지즙 마시면 복통이나 설사, 복통 등의 부작용이 발생하여 한꺼번에 대량으로 섭취하게 되므로 주의가 필요합니다.
같이 보면 좋은 글
감 효능 부작용
안녕하세요. 오늘은 감의 효능과 부작용에 대하여서 알아보도록 하겠습니다. 감 효능 1. 면역 강화 감에는 리코펜이 풍부하여 세균이나 바이러스의 침입을 방지합니다. 면역력을 강화하는 비타
cocon.tistory.com
양배추 효능
오늘은 양배추 효능에 대하여서 알아보도록 할 텐데요, 양배추는 여러 영양소가 있는 채소로 잘 알려져 있습니다. 그 외 삶으면 식감도 좋아지는데, 저는 쌈으로도 자주 먹었던 것 같습니다. 그
cocon.tistory.com